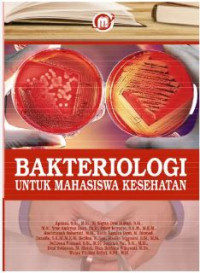
Image of Bakteriologi untuk mahasiswa kesehatan

Detail Cantuman
Advanced Search
BUKU TEXT KOLEKSI PERPUS
Bakteriologi untuk mahasiswa kesehatan
Tidak Tersedia Deskripsi
Ketersediaan
B002927Q1 | 616.9201 APR b | RAK KOLEKSI BUKU (3-F.2) | Tersedia |
B002927Q2 | 616.9201 APR b | RAK KOLEKSI BUKU (3-F.2) | Tersedia |
Informasi Detil
Judul Seri |
-
|
---|---|
No. Panggil |
616.9201 APR b
|
Penerbit | PT Masagena Mandiri Medica : Makasar., 2023 |
Deskripsi Fisik |
-
|
Bahasa |
Indonesia
|
ISBN/ISSN |
978-602-71107-6-2
|
Klasifikasi |
616.9201 APR b
|
Tipe Isi |
Text
|
Tipe Media |
Tercetak
|
---|---|
Tipe Pembawa |
-
|
Edisi |
-
|
Subyek | |
Info Detil Spesifik |
-
|
Pernyataan Tanggungjawab |
Maulin Inggraini, Noor Andryan Ilsan
|
Versi lain/terkait
Tidak tersedia versi lain